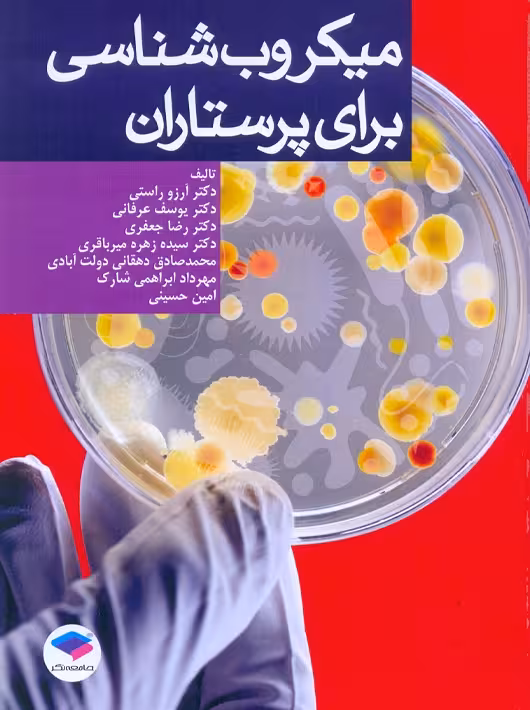

دستنامه ی بیهوشی چکیده ای جامع از مرجع پرستار بیهوشی جامعه نگر

بانک کتاب مارکا
دستنامه ی بیهوشی چکیده ای جامع از مرجع پرستار بیهوشی جامعه نگر
گزارش
محصولات مشابه

مرور جامع DRS پرستاری و بهداشت مادران و نوزادان جامعه نگر
224,100 تومان
میکروب شناسی برای پرستاران راستی جامعه نگر
211,000 تومان

درسنامه ایمونولوژی به زبان خودمانی جامعه نگر
215,100 تومان

تکنولوژی جراحی ENT فک و صورت ساداتی جامعه نگر
206,000 تومان

کتاب فیزیولوژی برای پرستاران نوشته فرناز نیکبخت _علی محمد خانی زاده_سارا حکیم زاده نشر جامعه نگر
219,000 تومان

اصول بیهوشی و مراقبت ها افرا جامعه نگر
214,000 تومان

مراقبت های پیش بیمارستانی تروما جلد 1 کوهستانی جامعه نگر
223,000 تومان

مدیریت کیفیت در مراکز بهداشتی درمانی مفاهیم اصول و روش ها جامعه نگر
224,100 تومان

پرستار بیهوشی 2018 جلد اول مسائل حرفه ای هوشبری و فارماکولوژی بیهوشی جامعه نگر
197,100 تومان

فارماکولوژی بالینی برای پرستاران به روش الگوریتمی محمودی جامعه نگر
203,000 تومان

راهنمای جامع روش تحقیق در علوم پزشکی جامعه نگر
224,100 تومان

کتاب تکنولوژی جراحی گوارش و غدد اتاق عمل , لیلا ساداتی و دکتر احسان گلچینی , ویرایش دوم , نشر جامعه نگر
189,000 تومان

مبانی پرستاری کوزیر و ارب تکامل دوره زندگی جلد 6 ویراست یازدهم برمن یکه فلاح جامعه نگر
196,000 تومان

راهنمای کامل داروهای بیهوشی ویراست دوم رضایی جامعه نگر
194,000 تومان

طراحی محاسباتی دارو یانگ رسول امینی فاطمه دباغ وثوق جامعه نگر
205,000 تومان

راهنمای بالینی تکنولوژی جراحی شادفر جامعه نگر
223,000 تومان

کتاب آشنایی با بیماری های داخلی اتاق عمل , دکتر مصطفی راد و دکتر حمید یزدی مقدم , ویرایش دوم , نشر جامعه نگر
189,000 تومان

برونر و سودارث پرستاری داخلی و جراحی 2022 جلد 8 ارتوپدی هینکل هاتفی مودب جامعه نگر
211,000 تومان

طب زیبایی و عملکردی در زنان و زایمان درمان های ترکیبی برای جوانسازی ولوواژینال مانتووانی نوروزی جامعه نگر
224,000 تومان

تغذیه درمانی در بیماری ها شیدفر جامعه نگر
205,000 تومان
بررسی تغییرات قیمت
دستنامه ی بیهوشی چکیده ای جامع از مرجع پرستار بیهوشی جامعه نگر
Hello, world! This is a toast message.

